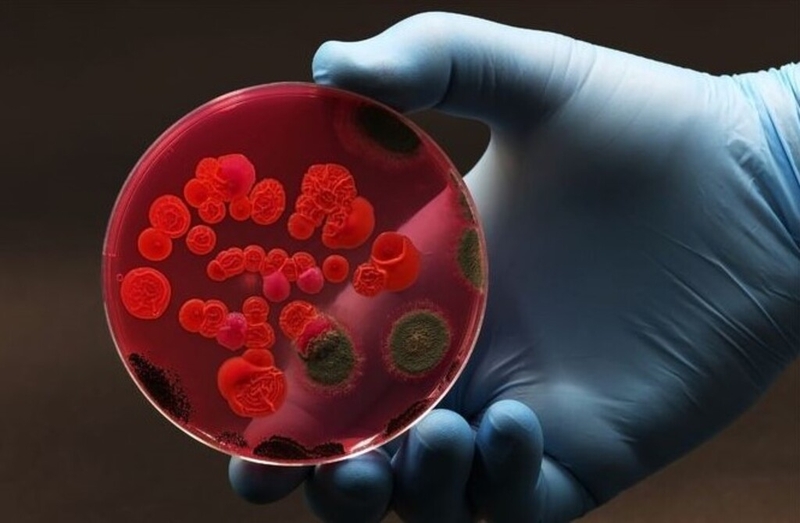
Chlamydia IgM là gì? Những điều cần biết về xét nghiệm Chlamydia IgM 1

Từng làm ở Viện ISDS, nhiều năm cộng tác với CDC Thái Nguyên triển khai dự án phòng chống HIV/AIDS, 2 năm cộng tác với WHO.
Ánh Vũ
24/02/2025
Mặc định
Lớn hơn
Chlamydia là căn bệnh lây truyền qua đường tình dục khá phổ biến ở cả 2 giới nam và nữ và xét nghiệm Chlamydia IgM là xét nghiệm giúp xác định sự hiện diện của kháng thể IgM chống lại vi khuẩn Chlamydia trachomatis trong máu. Vậy bạn hiểu gì về xét nghiệm Chlamydia IgM?
Thực tế cho thấy, không phải độc giả nào cũng hiểu rõ về xét nghiệm Chlamydia IgM. Vậy xét nghiệm Chlamydia IgM là gì? Trước khi tìm hiểu về xét nghiệm Chlamydia IgM, hãy cùng Nhà thuốc Long Châu tìm hiểu sơ qua về căn bệnh Chlamydia bạn nhé.
Chlamydia là một bệnh nhiễm trùng lây truyền qua đường tình dục (STI) do vi khuẩn Chlamydia trachomatis gây ra.
Không giống như nhiều loại vi khuẩn khác, Chlamydia trachomatis có chu kỳ phát triển đặc biệt, kéo dài từ 48 – 72 giờ. Trong thời gian này, vi khuẩn xâm nhập và ký sinh bắt buộc bên trong tế bào sống sau đó phá hủy tế bào và gây tổn thương niêm mạc. Vi khuẩn này tồn tại trong dịch tiết của âm đạo, niệu đạo và cổ tử cung. Do đó mà bệnh Chlamydia có thể lây lan dễ dàng qua quan hệ tình dục không an toàn qua đường âm đạo, hậu môn hoặc miệng. Ngoài ra, phụ nữ mang thai mắc Chlamydia cũng có thể truyền bệnh sang con trong quá trình sinh nở.
Chlamydia thường không có triệu chứng rõ ràng trong giai đoạn đầu do vậy mà nhiều người không nhận ra bản thân đã nhiễm bệnh. Chlamydia có thể chữa khỏi hoàn toàn nếu được phát hiện sớm và điều trị đúng cách. Bệnh thường được điều trị bằng kháng sinh.
Tuy có thể chữa khỏi hoàn toàn song nếu không được phát hiện và điều trị kịp thời, bệnh có thể gây ra nhiều biến chứng nguy hiểm, ảnh hưởng nghiêm trọng đến sức khỏe sinh sản nói riêng và sức khỏe tổng thể nói chung. Một số biến chứng của Chlamydia có thể kể đến như viêm vùng chậu, viêm mào tinh hoàn, nhiễm trùng tuyến tiền liệt, nhiễm trùng ở trẻ sơ sinh, thai ngoài tử cung…
Chlamydia IgM là gì? Nếu không phải người trong ngành y thì thật khó để có thể đưa ra được câu trả lời chính xác.
Như đã trình bày phía trên, Chlamydia là bệnh lây qua đường tình dục gây ra bởi vi khuẩn Chlamydia trachomatis. Trong y học, IgM (Immunoglobulin M) là loại kháng thể đầu tiên được tạo ra khi cơ thể phản ứng với một tác nhân kháng nguyên, chẳng hạn như nhiễm trùng mới. Khi có sự xâm nhập của vi khuẩn hoặc virus, IgM nhanh chóng xuất hiện trong huyết thanh, giúp hệ miễn dịch nhận diện và chống lại tác nhân gây bệnh.
Theo đó, xét nghiệm Chlamydia IgM là xét nghiệm giúp kiểm tra sự hiện diện của kháng thể IgM chống lại vi khuẩn Chlamydia trachomatis trong máu. Đây là một xét nghiệm huyết thanh học giúp phát hiện nhiễm trùng Chlamydia giai đoạn đầu hoặc mới mắc.
Xét nghiệm Chlamydia IgM có thể cho ra kết quả âm tính hoặc dương tính. Nếu:

Đến đây, chắc hẳn bạn đã phần nào giải đáp được thắc mắc xét nghiệm Chlamydia IgM là gì rồi phải không? Vậy khi nào cần thực hiện xét nghiệm Chlamydia IgM hay xét nghiệm Chlamydia IgM được chỉ định khi nào?
Xét nghiệm Chlamydia IgM được chỉ định trong các trường hợp sau:
Như đã trình bày phía trên, xét nghiệm Chlamydia IgM là một xét nghiệm máu nhằm phát hiện kháng thể IgM chống lại vi khuẩn Chlamydia trachomatis giúp chẩn đoán nhiễm trùng cấp tính.Trong xét nghiệm Chlamydia IgM, mẫu bệnh phẩm được sử dụng là huyết thanh của người bệnh. Vậy quy trình xét nghiệm Chlamydia IgM ra sao?
Về cơ bản quy trình xét nghiệm Chlamydia IgM sẽ được tiến hành như sau:
Thông thường, khi xét nghiệm Chlamydia IgM, bạn không cần nhịn ăn trước khi lấy máu. Tuy nhiên, bạn cần thông báo cho bác sĩ về bất kỳ loại thuốc nào bạn đang sử dụng bởi một số thuốc có thể ảnh hưởng đến kết quả xét nghiệm.
Nếu đang có triệu chứng nghi ngờ nhiễm Chlamydia, bạn có thể được bác sĩ chỉ định thêm các xét nghiệm khác như PCR, IgG hoặc xét nghiệm nước tiểu.
Để lấy mẫu bệnh phẩm, nhân viên y tế sẽ sử dụng kim tiêm để lấy một lượng máu từ tĩnh mạch ở cánh tay của người bệnh sau đó cho mẫu máu thu được vào ống nghiệm chuyên dụng và chuyển đến khoa xét nghiệm để xử lý.

Mẫu bệnh phẩm sau khi được đưa đến khoa xét nghiệm sẽ được ly tâm để tách huyết thanh – phần dịch trong của máu. Đây là nơi chứa các kháng thể IgM.
Sau khi tách được huyết thanh, huyết thanh sẽ được xử lý và phân tích thông qua các phương pháp như ELISA hoặc Western Blot để phát hiện kháng thể IgM chống lại Chlamydia trachomatis.
Qua quá trình phân tích mẫu bệnh phẩm, kết quả xét nghiệm Chlamydia IgM được đưa ra. Người bệnh chờ lấy kết quả và đem về đưa lại cho bác sĩ chuyên khoa.
Bác sĩ sau khi đọc kết quả sẽ giải thích cho người bệnh và đưa ra hướng xử trí phù hợp. Trong một số trường hợp, bác sĩ có thể yêu cầu xét nghiệm IgG hoặc PCR để có kết luận chính xác.

Trên đây là toàn bộ những thông tin cơ bản xoay quanh xét nghiệm Chlamydia IgM mà Nhà thuốc Long Châu muốn chia sẻ đến quý độc giả. Hy vọng, với những chia sẻ hôm nay, bạn đọc sẽ hiểu rõ hơn về loại xét nghiệm này và giải đáp được thắc mắc xét nghiệm Chlamydia IgM là gì. Nếu còn bất cứ băn khoăn nào về xét nghiệm Chlamydia IgM hãy để lại bình luận phía dưới bài viết để được hỗ trợ giải đáp sớm nhất.
Dược sĩ Đại học Nguyễn Tuấn Trịnh
Từng làm ở Viện ISDS, nhiều năm cộng tác với CDC Thái Nguyên triển khai dự án phòng chống HIV/AIDS, 2 năm cộng tác với WHO.